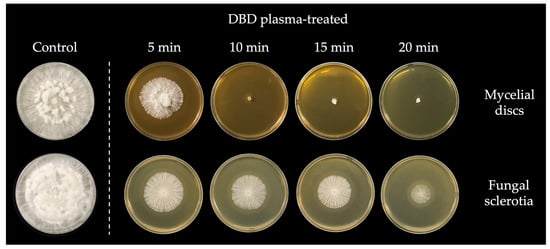

Abstract
Athelia rolfsii is one of the most destructive and aggressive fungal pathogens worldwide and causes southern blight disease of lettuce. A nonthermal atmospheric-pressure dielectric barrier discharge (DBD) plasma has attracted interest as an alternative control method to chemical usage because of its antimicrobial activity. Exposure of A. rolfsii to DBD plasma for 5, 10, 15, and 20 min resulted in in vitro fungal inhibition of mycelial discs and sclerotia. The results showed that DBD plasma exposure for 10 min completely inhibited fungal growth of mycelial discs, whereas exposure for over 20 min was required to inhibit the hyphal growth of sclerotia. Scanning electron microscopy (SEM) observations of mycelia and sclerotia abnormalities revealed laceration and damage of both mycelia and sclerotia. In addition, disease incidence and severity were reduced in mycelial and sclerotia inoculation following DBD plasma exposure for 15 and 20 min, respectively, compared with the positive control. In conclusion, the DBD plasma demonstrates antifungal activity against A. rolfsii via inhibition of fungal growth and reduction in disease incidence and severity. Therefore, DBD plasma has the potential to be applied in controlling southern blight disease of lettuce.
1. Introduction
Lettuce (Lactuca sativa L.) is one of the most economically important vegetable crops grown in Thailand and around the world. However, southern blight disease is one of the most common and destructive diseases affecting lettuce, leading to crop yield losses of up to 75% and, in some cases, the loss of entire fields [1].
Athelia rolfsii (anamorph Sclerotium rolfsii) is a necrotrophic, soilborne fungal plant pathogen that produces abundant white mycelia on infected plants [2]. This fungus is considered to be one of the most devastating fungal pathogens of various plant species, causing lettuce drop, stem rot, pod rot, southern blight, and damping-off diseases [3]. Plants in the family Brassicaceae are the main host plants for A. rolfsii infection [4]. Moreover, the disease is severe in the case of seedling infection, causing high economic losses [5].
Symptoms of southern blight disease include gray and water-soaked lesions on the stem above the soil line, which develop to a soft decay that eventually destroys the plant crown tissue and later causes collapse of the entire plant [6]. Additionally, the fungus produces abundant hyphae and sclerotia as asexual resting structures that facilitate pathogen survival in the absence of the host plant [2,6]. Sclerotia formed by the fungus serve as resting structures that secure fungal survival in soil for prolonged periods in the absence of a host plant and help to overcome periods of unsuitable growth conditions [7].
To control the disease, fungicides are often used, and biological control based on antagonistic microorganisms is also applied. However, fungicide usage leads to harmful effects and residues for plants, humans, and the environment, and biological control is less effective under field conditions [8].
Management of plant diseases in modern agriculture should include considerations from various points of view. Integrative approaches and technologies are one of those considerations for effective plant disease control strategies [9]. Recently, nonthermal or cold plasma technology has been applied in biology, medicine, dermatology, dentistry, agriculture, forestry, and the food industry [10,11,12]. Applications of nonthermal plasma (NTP) in agricultural research and industry have been widely reported, and the number of publications has been increasing in recent years. The topics include the alteration of seed-surface properties, the decontamination of seed borne pathogens, the degradation of mycotoxins, the stimulation of seed germination and seedling growth [13,14].
The NTP is an ionized gas and often referred to as the fourth state of matter [15]. It can be generated by passing gases through electric fields and produced using different discharge configurations, such as corona, micro-hollow cathode, gliding arc, atmospheric uniform glow, dielectric barrier discharge, and plasma jet and needle [16,17]. When a large amount of energy is applied to gas, it is transformed into a plasma state [15]. Plasma has frequently been demonstrated to be effective in microbial inactivation and cancer cell death. In contrast, plasma can also enhance cell differentiation, wound healing, seed germination, and plant growth [18,19]. The impact of plasma treatment can be varied by modulating the voltage, exposure time, and types of gases used for plasma generation [12].
Dielectric barrier discharge (DBD) plasma is an emerging novel technology that could potentially be used in microbial decontamination in humans, animals, plants, and foods [20,21]. Advantages of using DBD plasma include convenient operation in atmospheric conditions and the capability to treat the large surface area of targets with high efficiency [22]. The antimicrobial activity of DBD plasma is associated with the generation of large amounts of reactive oxygen species (ROS) that can directly affect microbial activity [23]. High concentrations of ROS, such as superoxide, hydroxyl ion, and hydrogen peroxide, are toxic to microbial cells and destroy them via oxidation of their macromolecules [24]. DBD plasma has been applied in inhibiting phytopathogens, mostly fungi and bacteria, under laboratory conditions and could reduce disease progress under greenhouse conditions, which means DBD plasma could be used as an alternative to chemical usage in fungicidal and bactericidal applications [25]. The NTP has been used to inactivate and disinfect plant pathogens, such as Gibberella fujikuroi on rice seeds, Rhizoctonia solani on brassicaceous seeds, Aspergillus parasiticus on post-harvest nuts, Ralstonia solanacearum on tomato seeds, and Xanthomonas campestris on cruciferous seeds [26,27,28,29]. In this study, we investigate the effects of applying nonthermal DBD plasma on the inhibition of Athelia rolfsii in terms of in vitro fungal growth inhibition and reductions in disease incidence and severity.
2. Materials and Methods
2.1. Source of the Fungus
Athelia rolfsii isolate KK-01 (GenBank accession no. OP404086), which was isolated from infected lettuce collected from Khon Kean Province in Northeast Thailand, was used to test the antifungal activity of DBD plasma.
2.2. DBD Plasma Device and Properties
A planar-type dielectric barrier discharge plasma device was used in this study, as shown in Figure 1a–c. The structure of the DBD plasma unit consisted of a 4 × 9 cm2 honeycomb-patterned high-voltage (HV) electrode, a full-plate ground electrode, and a 1 mm thickness alumina ceramic (Al2O3) dielectric barrier sandwiched between the two electrodes. Plasma from surrounding air was generated when a sinusoidal high voltage at peak-to-peak value of 6.2 kV, 18 kHz was applied. A HV probe (Tektronix, P6015A) and a current probe (PEARSON, 6585) were connected to measure the discharge voltage and current, respectively. The average electrical power dissipated in an AC cycle of air-discharged plasma was calculated from the expression
where T is the period of the waveform [30]. The DBD plasma was maintained at an average electrical power of 0.3 W/cm2 throughout the experiment. The device setup, DBD plasma during discharge, plasma exposure configuration for performing experiments, and air-discharged I–V are shown in Figure 1a–d, respectively.

Figure 1.
The DBD plasma device and its use in the fungal inhibition experiment: (a) DBD plasma device setup; (b) DBD plasma-generating discharge plate; (c) DBD plasma exposure on a fungal cultured Petri dish; (d) V (orange)–I (green) air discharge waveform; (e) typical OES of the DBD plasma.
The DBD plasma was configured using an optical emission spectroscopy (OES) device equipped with an Exemplar LS-Smart CCD spectrometer at a resolution of 1.5 nm. The air-discharged plasma was collected through an SMA-905 optical fiber 2.5 mm in diameter, and data were acquired covering the UV–visible range from 200 to 800 nm wavelength with 300 ms integration time. The typical spectra clearly show the dominant emission band of the hydroxide (OH) band (295 nm) and nitrogen (N2) second positive system, which are commonly found in air-discharged plasma or the discharge of inert gas in the air (Figure 1e). In plasma processing, most electrical energy dissipated in air DBD plasma is consumed in the excitation, ionization, and dissociation processes of N2 molecules [31]. In addition, a peak of atomic oxygen (O) at 777.4 nm was observed. These reactive plasma species further react with each other or with surrounding molecules to produce long-life reactive oxygen/nitrogen species (RONS), such as nitric oxide (NO), ozone (O3), hydroperoxyl (HO2), nitrous acid (HNO2), nitric acid (HNO3), and hydrogen peroxide (H2O2) in the plasma propagation region [31,32]. The generated RONS are delivered to the sample surface by diffusion and chemical processes within the plasma afterglow [33].
The concentrations of RONS in the gas phase were assessed as follows: O3 was determined using a 2B Technologies model 106-L ozone monitor (2B Technologies Inc., Boulder, CO, USA); for H2O2 and NO concentration, two gas detectors were employed: (1) model SKY2000–H2O2 (Shenzhen YuanTe Technology Co., Ltd., Shenzhen, China) and (2) model SKY2000–NO (Shenzhen YuanTe Technology Co., Ltd., Shenzhen, China). It was revealed that at the sample surface under the DBD plasma, the measurable concentrations of H2O2, NO, and O3 in the gas phase were 0.0, 0.1, and 6.5 ppm, respectively.
The DBD plasma device and properties was properly conducted and monitored in the conditioning room with 65% relative humidity (RH) at 25 °C. All measurements had been carried out repeatedly over 3 times to ensure the stability of plasma discharge and radicals’ emission before those samples to be exposed to.
2.3. DBD Plasma Treatment
The mycelial discs and sclerotia of A. rolfsii were treated with DBD plasma by exposure at 1.5–2.0 cm distance for 5, 10, 15, and 20 min on PDA plates with three biological replicates (Figure 1c). The plates were incubated at room temperature (25–28 °C) for 2 weeks. The radial growth of DBD-treated mycelial discs and sclerotia was compared with a non-treated control, which was calculated using the formula of Philippe et al. [34].
where dc is mean diameter of the colony in the control sample and dt is mean diameter of the colony in the treated sample.
2.4. Fungal Morphological Observation under Scanning Electron Microscopy (SEM)
SEM was used to observe effects of the DBD plasma on the fungal morphology. The mycelial discs and sclerotia from DBD plasma treatment and non-treated control were fixed in 2.5% glutaraldehyde diluted in 0.01 M phosphate-buffered saline (PBS) at 4 °C overnight. The samples were washed in 0.01 M PBS 3 times (10 min each). Then, the samples were dehydrated using serial ethanol at concentrations of 30%, 50%, 70%, 80%, 90%, and 100% for 15 min each. Subsequently, the sample alcohol was replaced in a critical point drying (CPD) machine. The samples were glow discharged, and SEM observations were conducted using a JSM-IT200 (Jeol, Tokyo, Japan).
2.5. Effects of DBD Plasma on Reduction in Disease Incidence and Severity of Southern Blight
The mycelial discs (5 discs/plant) and sclerotia (10 sclerotia/plant) from DBD plasma treatment and non-treated control were used to inoculate lettuce plants (14 days old), which were grown in a 5-inch pot with double autoclaved soil for observing fungal infection. The lettuce inoculated using a fungal-free culture disc was used as a healthy control. The plants were incubated in the growth chamber at 25 °C and 80% RH and a photoperiod of 12 h light and 12 h dark. Disease incidence was assessed at 7 and 14 days after inoculation according to the formula of Kripalini et al. [35] as follows:
Disease severity was assessed at 7 and 14 days after inoculation using a modified scale reported by Le et al. [36] as follows: severity score (1) no symptoms, healthy plant; (2) gray water-soaked lesions present on stem; (3) visible fungal outgrowth on stem base, characterized by silky-white mycelia or sclerotia that gradually darken soil but no visible fungal outgrowth; (4) partial wilting, where younger leaves begin to wilt and stems begin to shrivel; and (5) complete wilting, desiccation, and browning of leaves and stem: plant collapse and death. Each treatment contained 9 replications, and the experiment was repeated 3 times.
2.6. Statistical Analysis
All data in the present study were analyzed by using Statistix 8 (Analytical Software, Tallahassee, FL, USA). Data were analyzed using one-way analysis of variance (ANOVA), followed by the least significant difference (LSD) test (p < 0.05). Each treatment had three biological replicates. All data are expressed as mean ± standard deviation (SD).
3. Results
3.1. Fungal Inhibition by DBD Plasma
Both fungal mycelial discs and sclerotia were treated with the DBD plasma for 5, 10, 15, and 20 min, and the results showed that the percentage of inhibition of mycelial growth from mycelial discs was 30.33% at exposure to the DBD plasma for 5 min, whereas exposure for over than 10 min could completely inhibit fungal growth (100% inhibition) (Table 1 and Figure 2). Mycelial growth germinated from sclerotia was inhibited by 55.76, 65.45, 65.75, and 85.50% due to DBD plasma exposure for 5, 10, 15, and 20 min, respectively (Table 1 and Figure 2). All treatments were compared to a non-treated control. The results indicate that DBD plasma can effectively inhibit the mycelial growth of A. rolfsii.

Table 1.
Percentage of inhibition of Athelia rolfsii growth after exposure to DBD plasma.
Figure 2.
In vitro inhibition of Athelia rolfsii treated with the DBD plasma for different exposure durations. The results were photographed at 4 and 5 days after incubation for mycelial discs and sclerotia, respectively.
3.2. Fungal Morphology after DBD Plasma Exposure under SEM
Fungal morphology after the DBD plasma exposure was observed under SEM. The results reveal that mycelia and sclerotia that were exposed to DBD plasma for 5, 10, 15, and 20 min were damaged as evidenced by the laceration on the treated areas of fungal mycelia (Figure 3a–d) compared with the non-treated control, which showed normal mycelial characteristics (Figure 3e,f).

Figure 3.
Scanning electron micrographs of Athelia rolfsii mycelia (a–d) after exposure to DBD plasma for 5, 10, 15, and 20 min compared with the non-treated control (e,f). Mycelia treated with the DBD plasma showed characteristics of laceration, whereas mycelia from a non-treated control showed normal characteristics.
Sunken and lacerated surfaces were observed on the outer layers of the sclerotia exposed to DBD plasma for 5, 10, 15, and 20 min (Figure 4a–d) in contrast to the regular surfaces of sclerotium of the non-treated control (Figure 3e,f). Moreover, there was more severe damage to both mycelia and the sclerotia when DBD plasma was applied for longer periods. The results indicate that DBD plasma affects and destroys the mycelial structure and sclerotia surface of A. rolfsii, leading to a direct reduction in fungal viability.

Figure 4.
Scanning electron micrographs of sclerotia of Athelia rolfsii (a–d) after exposure to DBD plasma for 5, 10, 15, and 20 min compared with the non-treated control (e,f). Sclerotia exposed to DBD plasma showed lacerated and sunken surfaces, whereas sclerotia from the non-treated control showed regular surfaces.
3.3. Effects of DBD Plasma on Reduction in Disease Incidence and Severity of Southern Blight
Mycelial discs and sclerotia of A. rolfsii were exposed to DBD plasma for 5, 10, 15, and 20 min before being inoculated on lettuce for observation of fungal pathogenicity. The results show that at 7 days after inoculation, mycelial discs after exposure to the DBD plasma for over 15 min had no disease incidence (no plants were infected), and the disease severity was reduced from level 5 to level 1, equal to a healthy control. By contrast, positive control (non-treated) plants showed 100% disease incidence with disease severity level 5 (all plants died) (Table 2 and Table 3 and Figure 5a). At 14 days after inoculation, the disease incidence from DBD plasma exposure for over 15 min was zero, and the disease severity was reduced from level 5 to levels 2 and 1 due to DBD plasma exposure for 15 and 20 min, respectively (Table 2 and Table 3 and Figure 5c).

Table 2.
Disease incidence of southern blight on lettuce caused by Athelia rolfsii after DBD plasma exposure for different durations.

Table 3.
Disease severity of southern blight on lettuce caused by Athelia rolfsii after DBD plasma exposure for different durations.

Figure 5.
Pathogenicity assays of Athelia rolfsii after DBD plasma exposure, for different durations of 5, 10, 15, and 20 min, showing lettuce plants inoculated with (a) fungal mycelial discs at 7 days after inoculation; (b) sclerotia at 7 days after inoculation; (c) fungal mycelial discs at 14 days after inoculation; (d) sclerotia at 14 days after inoculation.
Moreover, the results of disease incidence and disease severity obtained from sclerotia inoculation were different from those of mycelial disc inoculation. At 7 days after inoculation, sclerotia treated with DBD plasma for 20 min had no disease incidence, whereas the disease incidence from treatments of the exposure to DBD plasma for shorter than 15 min and the positive control were at 100% (Table 2 and Table 3 and Figure 5b). In response to sclerotia inoculation, disease severity was level 1 for DBD plasma exposure for 15 and 20 min but was level 5 (all plants died) for DBD plasma exposure for 5 and 10 min and the positive control (Table 2 and Table 3 and Figure 5b). At 14 days after inoculation, disease incidence was 100% for treatments involving DBD plasma exposure for 5–15 min, whereas it was 33.33% for DBD plasma exposure for 20 min (Table 2 and Figure 5d). As mentioned, the disease severity was level 5 for treatments involving DBD plasma exposure for 5 and 10 min, which was equal to the positive control; the disease severity was reduced from level 5 to level 4 for treatments involving longer DBD plasma exposure, for 15 and 20 min (Table 3 and Figure 5d).
Mycelial growth from inoculated discs and sclerotia were observed after 7 and 14 days of inoculation. The results showed that, for mycelial disc inoculation, white mycelia grew out of the disc in the positive control (all lettuce plants died), as well as for treatments involving DBD plasma exposure for 5 and 10 min (some lettuce plants had rotted and collapsed), whereas no mycelial growth was observed for treatments involving DBD plasma exposure for 15 and 20 min (Figure 6a). Moreover, the formation of sclerotia was observed at 7 days after inoculation for the positive control and at 14 days after inoculation for the treatment with DBD plasma exposure for 5 min, but no sclerotia formation was observed for treatments involving DBD plasma exposure for over 10 min even at 14 days after inoculation (Figure 6a). The results indicate that DBD plasma exposure delays the formation of sclerotia of A. rolfsii.

Figure 6.
Characteristics and growth of mycelial discs and sclerotia, which were inoculated to lettuce after exposure to the DBD plasma at 5, 10, 15, and 20 min, photographed at 7 and 14 days after (a) mycelial disc inoculation (the formation of sclerotia is indicated by red arrows) and (b) sclerotia inoculation.
Fungal growth from sclerotia inoculation at 7 days after inoculation was observed as white mycelial growth from sclerotia of the positive control (all lettuce plants died) and treatments involving exposure to the DBD plasma for 5 and 10 min (some lettuce plants had rotted and collapsed), while mycelia from treatments involving exposure to the DBD plasma for 15 and 20 min had slight growth (Figure 6b). At 14 days after inoculation, mycelia from treatments involving exposure to the DBD plasma for 15 and 20 min demonstrated obvious growth (Figure 6b). The results indicate that DBD plasma exposure for over 15 min delays mycelial growth from sclerotia and reduces the disease incidence and disease severity in inoculated plants.
4. Discussion
A. rolfsii is a serious fungal pathogen infecting various vegetable plants worldwide. The fungus can survive as sclerotia for many years in the soil and employs a wide array of cell wall-degrading enzymes and oxalic acid to colonize its hosts [1,6]. Because of its wide host range, fast growth rate, high aggression, and the production of large numbers of mycelia and persistent sclerotia, A. rolfsii is problematic to control [37]. Current control measures comprise the use of resistant cultivars and various physical, chemical, and biological control strategies [8]. Here, we presented a DBD plasma as a novel control strategy for southern blight disease of lettuce.
The results of inactivation of mycelia and sclerotia of A. rolfsii were different. To inactivate fungal growth in vitro, the DBD plasma inhibited mycelial growth completely after 10 min exposure while the growth of sclerotia could not be completely inhibited even after exposure to the DBD plasma for 20 min. Accordingly, the effects of DBD plasma exposure on the morphological structure of mycelia, observed under SEM, were more severe than on sclerotia because the structure of mycelia is comparatively thinner and less complex [7]. Sclerotia are resistant to physical, chemical, and biological degradation and thus facilitate long-term fungal survival in soil [38]. Sclerotia have a significant function in the biological cycle and infectivity of sclerotia-formed fungi since they are the main propagule for fungal dispersion [4].
The mechanisms of NTP in microorganism inhibition are completely different from those of classical decontamination techniques. Antimicrobial activity can be achieved either by UV irradiation, leading to the elimination of microorganisms through photon-induced desorption resulting from breaking chemical bonds in cell molecules, or by etching due to highly energetic ions and reactive species through bombarding and reactions with the surface of the treated cells [23,39]. Once the outer layers of the cell are damaged and cellular integrity is compromised, the UV photons can come into direct contact with genetic material, leading to DNA damage that often results in the loss of viability. Direct DNA damage of microbial cells or spores cannot lead to sterilization [40]. In atmospheric plasma, reactive species such as O, OH, and NO2 are believed to play an important role in decontamination of microorganisms [41]. The lacerated and damaged mycelia and sclerotia after exposure to the DBD plasma, as observed by SEM, appear to be responsible for consequent reductions in the incidence and severity of southern blight disease caused by A. rolfsii in inoculated plants.
One may find plasma catalysis to be analogous to the above-mentioned process; it involves the use of plasma to generate reactive oxygen species (ROS) and reactive nitrogen species (RNS) [42], which typically induce reaction to cellular components such as DNA and proteins, leading to cell necrosis or apoptosis.
Plasma catalysis is a technique that uses plasma, or ionized gas, to catalyze chemical reactions. This technique has the potential to be safe and play an important role in a variety of fields, including energy and the environment. In the energy field, plasma catalysis has been explored to improve the efficiency of fuel cells and to produce “green” hydrogen fuel directly from water. In the environmental field, plasma catalysis has been used to treat waste gases, such as those produced by power plants and factories, to reduce the emission of harmful pollutants. As it has the capability not to produce any toxic or hazardous by-products, its potential is more energy efficient than traditional catalytic processes, which could help to reduce greenhouse gas emissions.
The efficacy of the DBD plasma on in vivo reduction of incidence and severity of southern blight disease showed that both disease incidence and severity were significantly decreased compared to the positive control. According to the results of in vitro inhibition, disease incidence and severity of sclerotia inoculation were higher than those of mycelia inoculation. The results were collected at 7 and 14 days after inoculation (DAI) because at 7 DAI, some inoculated plants started to die but not were completely collapsed and at 14 DAI all inoculated plants had died completely. As of the results, the infection of fungal sclerotia was more aggressive than that of mycelial infection. Therefore, to control the infection of fungal sclerotia, which is the main infecting and surviving structure, the time of the DBD plasma exposure had to be extended.
The DBD plasma has been tested in the inhibition of many fungal phytopathogens, such as Alternaria alternata, Aspergillus flavus, Aspergillus oryzae, Fusarium culmorum, and Fusarium oxysporum f. sp. lycopersici, resulting in complete inhibition of spore germination and hyphal growth [22,43,44,45]. The incidence and severity of diseases induced by plasma-treated fungi were strongly reduced and the percentage of plant survival was increased [19]. Moreover, in this study, the incidence and severity of southern blight disease were reduced and the survival of lettuce plants was increased. This evidence indicates that DBD plasma is a promising and effective method for fungal inactivation or inhibition with a broad spectrum of highly effective antifungal activity. To the best of our knowledge, this is the first reported application of nonthermal DBD plasma on inhibition of A. rolfsii, the causative fungal agent of southern blight disease in lettuce.
5. Conclusions
Application of NTP DBD with a plasma power density of 0.3 W/cm2 for over 10 min was found to be able to inhibit mycelial growth of A. rolfsii. The damage to fungal mycelia and sclerotia was observed under SEM, with laceration in plasma-treated areas. Moreover, the disease incidence and severity were reduced after inoculation with mycelial discs and sclerotia that had been exposed to DBD plasma for over 15 min. As shown by the results, the NTP DBD plasma can be used as a fungal disinfectant for inactivation of A. rolfsii, which causes southern blight disease in lettuce.
Author Contributions
Conceptualization, S.S., C.S. and W.S.; methodology, S.S.; validation, S.S. and O.-U.R.; formal analysis, S.S.; investigation, S.S. and O.-U.R.; resources, O.-U.R. and D.B.; data curation, S.S.; writing—original draft preparation, S.S. and D.B.; writing—review and editing, S.S., O.-U.R. and D.B.; visualization, S.S.; supervision, O.-U.R., C.S. and D.B.; project administration, W.S.; funding acquisition, C.S. and D.B. All authors have read and agreed to the published version of the manuscript.
Funding
This research project was supported by Fundamental Fund 2022, Chiang Mai University, grant number FF65/117.
Institutional Review Board Statement
Not applicable.
Informed Consent Statement
Not applicable.
Data Availability Statement
Not applicable.
Conflicts of Interest
The authors declare no conflict of interest.
References
- Mamo, B.E.; Eriksen, R.L.; Adhikari, N.D.; Hayes, R.J.; Mou, B.; Simko, I. Epidemiological Characterization of Lettuce Drop (Sclerotinia spp.) and Biophysical Features of The Host Identify Soft Stem as A Susceptibility Factor. PhytoFrontiers 2021, 1, 182–204. [Google Scholar] [CrossRef]
- Adams, P.B.; Ayers, W.A. Ecology of Sclerotinia Species. Phytopathology 1979, 69, 896–899. [Google Scholar] [CrossRef]
- Mahadevakumar, S.; Yadav, V.; Tejaswini, G.S.; Janardhana, G.R. Morphological and Molecular Characterization of Sclerotium rolfsii Associated with Fruit Rot of Cucurbita maxima. Eur. J. Plant Pathol. 2016, 145, 215–219. [Google Scholar] [CrossRef]
- Tejaswini, G.S.; Mahadevakumar, S.; Sowmya, R.; Deepika, Y.S.; Meghavarshinigowda, B.R.; Nuthan, B.R.; Sharvani, K.A.; Amruthesh, K.N.; Sridhar, K.R. Molecular Detection and Pathological Investigations on Southern Blight Disease Caused by Sclerotium rolfsii on Cabbage (Brassica oleracea var. capitata): A New Record in India. J. Phytopathol. 2022, 170, 363–372. [Google Scholar] [CrossRef]
- El-Ashmony, R.M.S.; Zaghloul, N.S.S.; Milošević, M.; Mohany, M.; Al-Rejaie, S.S.; Abdallah, Y.; Galal, A.A. The Biogenically Efficient Synthesis of Silver Nanoparticles Using the Fungus Trichoderma harzianum and Their Antifungal Efficacy Against Sclerotinia sclerotiorum and Sclerotium rolfsii. J. Fungi 2022, 8, 597. [Google Scholar] [CrossRef]
- Mullen, J. Southern Blight, Southern Stem Blight, White Mold. Plant Health Instr. 2001. [Google Scholar] [CrossRef]
- Ordonez-Valencia, C.; Ferrera-Cerrato, R.; Quintanar-Zuniga, R.E.; Flores-Ortiz, C.M.; Guzman, G.J.M.; Alarcon, A.; Larsen, J.; Garcia-Barradas, O. Morphological Development of Sclerotia by Sclerotinia sclerotiorum: A View from Light and Scanning Electron Microscopy. Ann. Microbiol. 2015, 65, 765–770. [Google Scholar] [CrossRef]
- Lamichhane, J.R.; Durr, C.; Schwanck, A.A.; Robin, M.H.; Sarthou, J.P.; Cellier, V.; Messean, A.; Aubertot, J.N. Integrated Management of Damping-Off Diseases. A Review. Agron. Sustain. Dev. 2017, 37, 10–35. [Google Scholar] [CrossRef]
- Yodpitak, S.; Mahatheeranont, S.; Boonyawan, D.; Sookwong, P.; Roytrakul, S.; Norkaew, O. Cold Plasma Treatment to Improve Germination and Enhance the Bioactive Phytochemical Content of Germinated Brown Rice. Food Chem. 2019, 298, 328–339. [Google Scholar] [CrossRef]
- Fridman, G. Non-equilibrium Plasmas in Biology and Medicine. In Biological and Environmental Application of Gas Discharge Plasmas; Brelles, M.G., Ed.; California State Polytechnic University, Pomona: Claremont, CA, USA, 2012; pp. 95–184. [Google Scholar]
- Attri, P.; Ishikawa, K.; Okumura, T.; Koga, K.; Masaharu, S.M. Plasma Agriculture from Laboratory to Farm: A Review. Processes 2020, 8, 1002. [Google Scholar] [CrossRef]
- Domonkos, M.; Tichá, P.; Trejbal, J.; Demo, P. Applications of Cold Atmospheric Pressure Plasma Technology in Medicine, Agriculture and Food Industry. Appl. Sci. 2021, 11, 4809. [Google Scholar] [CrossRef]
- Zhang, J.J.; Kwon, T.; Kim, S.B.; Jeong, D.K. Plasma Farming: Non-Thermal Dielectric Barrier Discharge Plasma Technology for Improving the Growth of Soybean Sprouts and Chickens. Plasma 2018, 1, 285–296. [Google Scholar] [CrossRef]
- Mildaziene, V.; Sera, B. Effects of Non-Thermal Plasma Treatment on Plant Physiological and Biochemical Processes. Plants 2022, 11, 1018. [Google Scholar] [CrossRef]
- Adamovich, I.; Baalrud, S.D.; Bogaerts, A.; Bruggeman, P.J.; Cappelli, M.; Colombo, V.; Czarnetzki, U.; Ebert, U.; Eden, J.G.; Favia, P.; et al. The 2017 Plasma Roadmap: Low Temperature Plasma Science and Technology. J. Phys. D 2017, 50, 323001. [Google Scholar] [CrossRef]
- Conrads, H.; Schmidt, M. Plasma Generation and Plasma Sources. Plasma Sources Sci. Technol. 2000, 9, 441. [Google Scholar] [CrossRef]
- Moreau, M.; Orange, N.; Feuilloley, M.G.J. Non-Thermal Plasma Technologies: New Tools for Bio-Decontamination. Biotechnol. Adv. 2008, 26, 610–617. [Google Scholar] [CrossRef]
- Adhikari, B.; Pangomm, K.; Veerana, M.; Mitra, S.; Park, G. Plant Disease Control by Non-Thermal Atmospheric-Pressure Plasma. Front. Plant Sci. 2020, 11, 77. [Google Scholar] [CrossRef]
- Chutsirimongkol, C.; Boonyawan, D.; Polnikorn, N.; Techawatthanawisan, W.; Kundilokchai, T.; Bunsaisup, C.; Rummaneethorn, P.; Kirdwichai, W.; Chuangsuwanich, A.; Powthong, P. Non-Thermal Atmospheric Dielectric Barrier Discharge Plasma, Medical Application Studies in Thailand. Plasma Med. 2016, 6, 429–446. [Google Scholar] [CrossRef]
- Vajpayee, M.; Singh, M.; Ledwani, L.; Prakash, R.; Nema, S.K. Investigation of Antimicrobial Activity of DBD Air Plasma-Treated Banana Fabric Coated with Natural Leaf Extracts. ACS Omega 2020, 5, 19034–19049. [Google Scholar] [CrossRef]
- Alhazime, A.A. Generation and Characterization of Atmospheric Pressure Dielectric Barrier Discharge Air Plasma and Its Antifungal Potential: A Case Study on Alternaria alternata. J. Taibah Univ. Sci. 2021, 15, 1168–1177. [Google Scholar] [CrossRef]
- Ambrico, P.F.; Simek, M.; Rotolo, C.; Morano, M.; Minafra, A.; Ambrico, M.; Pollastro, S.; Gerin, D.; Faretra, F.; De Miccolis Angelini, R.M. Surface Dielectric Barrier Discharge Plasma: A Suitable Measure Against Fungal Plant Pathogens. Sci. Rep. 2020, 10, 3673. [Google Scholar] [CrossRef] [PubMed]
- Torres, M.A.; Jones, D.G.; Dangl, J.L. Reactive Oxygen Species Signaling in Response to Pathogens. Plant Physiol. 2006, 141, 373–378. [Google Scholar] [CrossRef] [PubMed]
- Veerana, M.; Yu, N.-N.; Ketya, W.; Park, G. Application of Non-Thermal Plasma to Fungal Resources. J. Fungi 2022, 8, 102. [Google Scholar] [CrossRef] [PubMed]
- Jo, Y.K.; Cho, J.; Tsai, T.C.; Staack, D.; Kang, M.H.; Roh, J.H.; Shin, D.B.; Cormwell, W.; Gross, D. A Non-Thermal Plasma Seed Treatment Method for Management of a Seedborne Fungal Pathogen on Rice Seed. Crop Sci. 2014, 54, 796–803. [Google Scholar] [CrossRef]
- Nishioka, T.; Takai, Y.; Kawaradani, M.; Okada, K.; Tanimoto, H.; Misawa, T.; Kusakari, S. Seed Disinfection Effect of Atmospheric Pressure Plasma and Low-Pressure Plasma on Rhizoctonia solani. Biocontrol Sci. 2014, 19, 99–102. [Google Scholar] [CrossRef] [PubMed]
- Basaran, P.; Basaran-Akgul, N.; Oksuz, L. Elimination of Aspergillus parasiticus from Nut Surface with Low Pressure Cold Plasma (LPCP) Treatment. Food Microbiol. 2008, 25, 626–632. [Google Scholar] [CrossRef]
- Jiang, J.; Lu, Y.; Li, J.; Li, L.; He, X.; Shao, H.; Dong, Y. Effect of Seed Treatment by Cold Plasma on the Resistance of Tomato to Ralstonia solanacearum (bacterial wilt). PLoS ONE 2014, 9, e97753. [Google Scholar] [CrossRef]
- Nishioka, T.; Takai, Y.; Mishima, T.; Kawaradani, M.; Tanimoto, H.; Okada, K.; Misawa, T.; Kurasaki, S. Low-Pressure Plasma Application for the Inactivation of the Seed-Borne Pathogen Xanthomonas campestris. Biocontrol Sci. 2016, 21, 37–43. [Google Scholar] [CrossRef]
- Tucekova, Z.K.; Vacek, L.; Krumpolec, R.; Kelar, J.; Zemánek, M.; Cernsk, M.; Ruzicka, F. Multi-Hollow Surface Dielectric Barrier Discharge for Bacterial Biofilm Decontamination. Molecules 2021, 26, 910. [Google Scholar] [CrossRef]
- Lu, X.; Naidis, G.V.; Laroussi, M.; Reuter, S.; Graves, D.B.; Ostrikov, K. Reactive Species in Non-Equilibrium Atmospheric-Pressure Plasmas: Generation, Transport, and Biological Effects. Phys. Rep. 2016, 630, 1–84. [Google Scholar] [CrossRef]
- Zhou, Z.; Zhou, R.; Prasad, K.; Fang, Z.; Speight, R.; Bazaka, K.; Ostrikov, K. Cold Atmospheric Plasma Activated Water as a Prospective Disinfectant: The Crucial Role of Peroxynitrite. Green Chem. 2018, 20, 5276–5284. [Google Scholar] [CrossRef]
- Perinban, S.; Orsat, V.; Raghavan, V. Nonthermal Plasma–Liquid Interactions in Food Processing: A Review. Compr. Rev. Food Sci. Food Saf. 2019, 18, 1985–2008. [Google Scholar] [CrossRef]
- Philippe, S.; Souaibou, F.; Guy, A.; Sebastien, D.T.; Boniface, Y.; Paulin, A.; Issaka, Y.; Dominique, S. Chemical Composition and Antifungal Activity of Essential Oil of Fresh Leaves of Ocimum gratissimum from Benin Against Six Mycotoxigenic Fungi Isolated from Traditional Cheese Wagashi. Res. J. Biol. Sci. 2012, 1, 22–27. [Google Scholar]
- Kripalini, N.; Biswas, M.K.; Devi, S.; Sinha, B. Studies on Survey of Fusarium wilt of Pea (Pisum sativum L.) and Its Management by Native Trichoderma Isolates and Commercial Trichoderma under Pot Condition in Manipur. Int. J. Bio-Resour. Stress Manag. 2019, 10, 001–008. [Google Scholar] [CrossRef]
- Le, C.N.; Mendes, R.; Kruijt, M.; Raaijmakers, J.M. Genetic and Phenotypic Diversity of Sclerotium rolfsii in Groundnut Fields in Central Vietnam. Plant Dis. 2012, 96, 389–397. [Google Scholar] [CrossRef]
- Lakpale, N.; Khare, N.; Thrimurty, V.S. Suppression of Sclerotium rolfsii Sacc.: An Integrated Approach. Soils Crops 2007, 17, 241–245. [Google Scholar]
- Bolton, M.D.; Thomma, B.P.H.J.; Nelson, B.D. Sclerotinia sclerotiorum (Lib) de Bary: Biology and Molecular Traits of a CosmoPolitan Pathogen. Mol. Plant Pathol. 2006, 7, 1–16. [Google Scholar] [CrossRef]
- Moisan, M.; Barbeau, J.; Crevier, M.C.; Pelletier, J.; Philip, N.; Saoudi, B. Plasma Sterilization. Methods and Mechanisms. Pure Appl. Chem. 2002, 74, 349–358. [Google Scholar] [CrossRef]
- Polcic, P.; Machala, Z. Effects of Non-Thermal Plasma on Yeast Saccharomyces cerevisiae. Int. J. Mol. Sci. 2021, 22, 2247. [Google Scholar] [CrossRef]
- Volkov, A.G.; Xu, K.G.; Kolobov, V.I. Plasma-Generated Reactive Oxygen and Nitrogen Species Can Lead to Closure, Locking and Constriction of the Dionaea muscipula Ellis Trap. J. R. Soc. Interface 2019, 16, 20180713. [Google Scholar] [CrossRef]
- Kim, H.H.; Teramoto, Y.; Ogata, A.; Takagi, H.; Nanba, T. Plasma Catalysis for Environmental Treatment and Energy Applications. Plasma Chem. Plasma Process. 2016, 36, 45–72. [Google Scholar] [CrossRef]
- Avramidis, G.; Stüwe, B.; Wascher, R.; Bellmann, M.; Wieneke, S.; von Tiedemann, A.; Viol, W. Fungicidal Effects of an Atmospheric Pressure Gas Discharge and Degradation Mechanisms. Surf. Coat. Technol. 2010, 205, S405–S408. [Google Scholar] [CrossRef]
- Panngom, K.; Lee, S.H.; Park, D.H.; Sim, G.B.; Kim, Y.H.; Uhm, H.S.; Park, G.; Choi, E.H. Non-Thermal Plasma Treatment Diminishes Fungal Viability and Up-Regulates Resistance Genes in a Plant Host. PLoS ONE 2014, 9, e99300. [Google Scholar] [CrossRef] [PubMed]
- Julak, J.; Souskova, H.; Scholtz, V.; Kvasnickova, E.; Savicka, D.; Kriha, V. Comparison of Fungicidal Properties of Non-Thermal Plasma Produced by Corona Discharge and Dielectric Barrier Discharge. Folia Microbiol. 2018, 63, 63–68. [Google Scholar] [CrossRef]
Disclaimer/Publisher’s Note: The statements, opinions and data contained in all publications are solely those of the individual author(s) and contributor(s) and not of MDPI and/or the editor(s). MDPI and/or the editor(s) disclaim responsibility for any injury to people or property resulting from any ideas, methods, instructions or products referred to in the content. |
© 2023 by the authors. Licensee MDPI, Basel, Switzerland. This article is an open access article distributed under the terms and conditions of the Creative Commons Attribution (CC BY) license (https://creativecommons.org/licenses/by/4.0/).